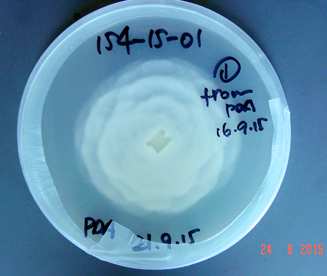

Disease Testing
As sports turf consultants we are able to test for all turf diseases. We are also one of the few companies who can test for the pythium variety present.
This can have a huge impact on the efficacy of any pythium control programme.
Pythium Root Dysfunction.
Current Pythium fungicides almost all show no activity against Pythium root dysfunction.
The only treatments that show efficacy is Segway.
This means that unless the correct diagnosis is made that you can spend thousands of dollars with little result by using the wrong fungicide.
Fungicides that you apply as part of a preventative program are usually more effective than those you apply in a curative program.
In the case of Pythium root rot, applications of commercial fungicides that contain ethazole, mefenoxam, fosetyl-AL or propamocarb are all more effective when this disease is a chronic problem in the turf.
Fungicides that target Pythium sp can be applied in recommended tank mixes and rotated among appropriate chemical groups.
Resistance to strobilurins, mefenoxam, and propamocarb has been seen in Pythium sp.
Repeated use of fungicides with the same mode of action favours the development of fungicide resistance.